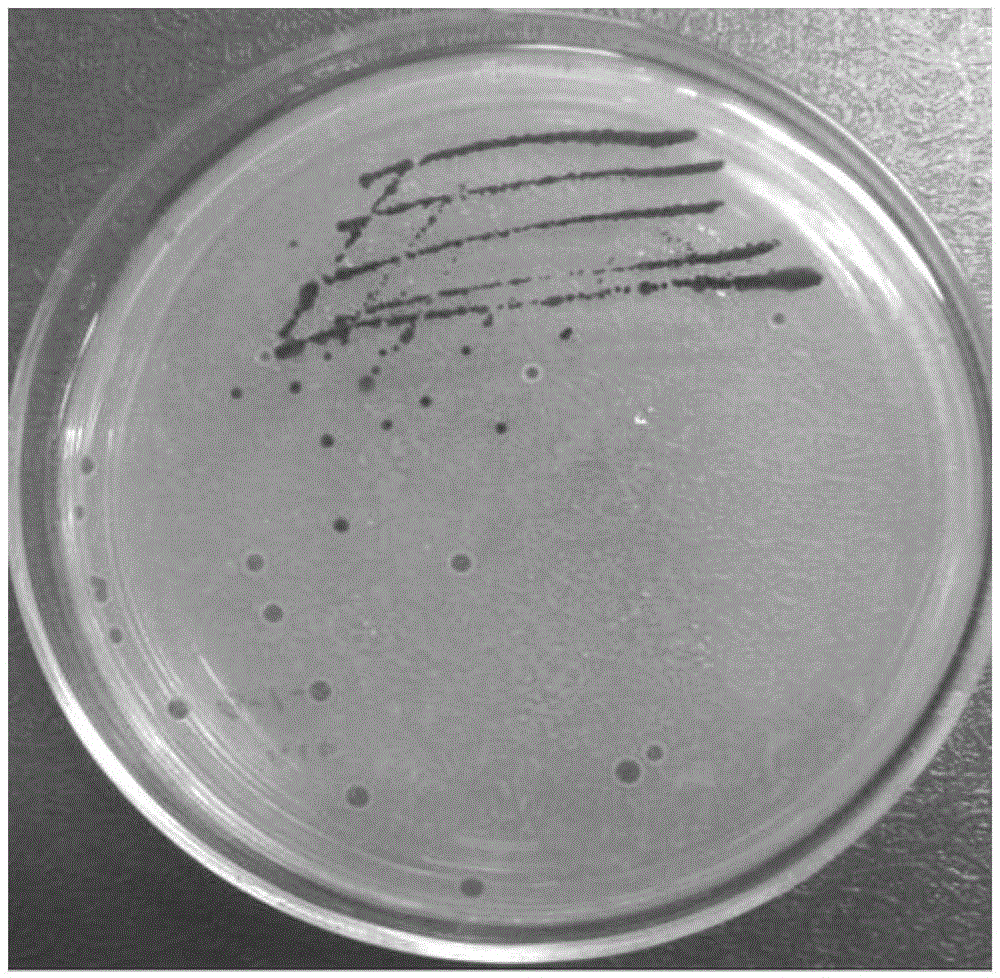
晶瑞电材获得发明专利授权：“一种过氧化氢的提纯方法”

晶瑞电材获得发明专利授权:“一种过氧化氢的提纯方法”
证券之星消息,根据天眼查APP数据显示晶瑞电材(300655)新获得一项发明专利授权,专利名为“一种过氧化氢的提纯方法”,专利申请号为CN202310161250.2,授权日为2025年4月18日。
图片来源于网络,如有侵权,请联系删除
专利摘要:本发明公开了一种过氧化氢的提纯方法,以工业级过氧化氢为原料,将其浓度调节至30%?40%,并控制体系进料温度为0?5℃,使处理后的过氧化氢依次流经串联设置的n个有机物处理单元;每个处理单元均包括依次连通的超声波处理装置、膜过滤装置,在每个处理单元中,过氧化氢依次经超声波振荡处理、膜过滤处理;控制过氧化氢在后一级超声波处理装置中的停留时间大于前一级超声波处理装置中的停留时间;控制后一级膜过滤装置的滤芯的孔径小于前一级膜过滤装置的滤芯的孔径;该方法在去除有机物阶段不需要额外再经过树脂塔,使进入后续去除阴阳离子树脂塔内的过氧化氢有较高的纯度,提高后续树脂塔的寿命,有机物的含量可降低至10ppb以下。

图片来源于网络,如有侵权,请联系删除
今年以来晶瑞电材新获得专利授权2个,较去年同期增加了100%。结合公司2024年中报财务数据,2024上半年公司在研发方面投入了5064.93万元,同比增70.62%。

图片来源于网络,如有侵权,请联系删除
数据来源:天眼查APP
以上内容为证券之星据公开信息整理,由智能算法生成(网信算备310104345710301240019号),不构成投资建议。
目录 返回
首页
